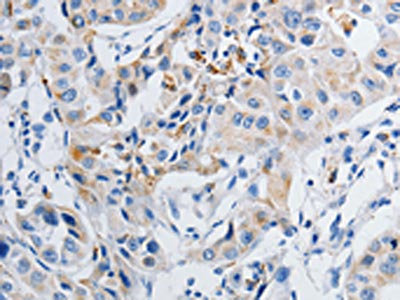

GRIA3 Antibody
-
中文名稱:GRIA3兔多克隆抗體
-
貨號:CSB-PA100222
-
規格:¥1100
-
圖片:
-
The image on the left is immunohistochemistry of paraffin-embedded Human ovarian cancer tissue using CSB-PA100222(GRIA3 Antibody) at dilution 1/50, on the right is treated with synthetic peptide. (Original magnification: ×200)
-
The image on the left is immunohistochemistry of paraffin-embedded Human lung cancer tissue using CSB-PA100222(GRIA3 Antibody) at dilution 1/50, on the right is treated with synthetic peptide. (Original magnification: ×200)
-
-
其他:
產品詳情
-
Uniprot No.:
-
基因名:
-
別名:AMPA 3 antibody; AMPA selective glutamate receptor 3 antibody; AMPA-selective glutamate receptor 3 antibody; dJ1171F9.1 antibody; GluA3 antibody; GLUK3 antibody; GluR 3 antibody; GLUR C antibody; GLUR K3 antibody; GluR-3 antibody; GluR-C antibody; GluR-K3 antibody; GLUR3 antibody; GLURC antibody; Glutamate ionotropic receptor AMPA type subunit 3 antibody; Glutamate receptor 3 antibody; Glutamate receptor C antibody; Glutamate receptor ionotrophic AMPA 3 antibody; Glutamate receptor ionotropic antibody; Glutamate receptor subunit 3 antibody; Glutamate receptor; ionotropic; AMPA 3 antibody; GRIA 3 antibody; Gria3 antibody; GRIA3_HUMAN antibody; Ionotrophic Glutamate Receptor antibody; MRX94 antibody
-
宿主:Rabbit
-
反應種屬:Human,Mouse,Rat
-
免疫原:Synthetic peptide of Human GRIA3
-
免疫原種屬:Homo sapiens (Human)
-
標記方式:Non-conjugated
-
抗體亞型:IgG
-
純化方式:Antigen affinity purification
-
濃度:It differs from different batches. Please contact us to confirm it.
-
保存緩沖液:-20°C, pH7.4 PBS, 0.05% NaN3, 40% Glycerol
-
產品提供形式:Liquid
-
應用范圍:ELISA,IHC
-
推薦稀釋比:
Application Recommended Dilution ELISA 1:1000-1:5000 IHC 1:25-1:100 -
Protocols:
-
儲存條件:Upon receipt, store at -20°C or -80°C. Avoid repeated freeze.
-
貨期:Basically, we can dispatch the products out in 1-3 working days after receiving your orders. Delivery time maybe differs from different purchasing way or location, please kindly consult your local distributors for specific delivery time.
-
用途:For Research Use Only. Not for use in diagnostic or therapeutic procedures.
相關產品
靶點詳情
-
功能:Receptor for glutamate that functions as ligand-gated ion channel in the central nervous system and plays an important role in excitatory synaptic transmission. L-glutamate acts as an excitatory neurotransmitter at many synapses in the central nervous system. Binding of the excitatory neurotransmitter L-glutamate induces a conformation change, leading to the opening of the cation channel, and thereby converts the chemical signal to an electrical impulse. The receptor then desensitizes rapidly and enters a transient inactive state, characterized by the presence of bound agonist. In the presence of CACNG4 or CACNG7 or CACNG8, shows resensitization which is characterized by a delayed accumulation of current flux upon continued application of glutamate.
-
基因功能參考文獻:
- Results suggest a role for GluA3 channel activity in the regulation of sleep behavior in both mice and humans. PMID: 29016847
- miR-330-3p up-regulated the total DNA methylation in non-small cell lung cancer cells, and co-IP-demonstrated GRIA3 was directly related with DNMT1 and DNMT3A. GRIA3 is a direct target of miR-330-3p. PMID: 28629431
- This study showed the lower GluA3 mRNA levels in pregnant women. PMID: 28284346
- the impaired surface expression of homomeric GluA3 receptors is caused by nonproductive assembly and aggregation to which LBD residues Tyr-454 and Arg-461 strongly contribute. PMID: 26912664
- This study demonstrated that the GRIA3 protein was altered in auditory cortex patient with schizophreia. PMID: 25433904
- An association was observed in migraine patients with the GRIA3 single nucleotide polymorphism rs3761555. PMID: 23772601
- The ionotrophic glutamate receptors AMPA3 and AMPA3 were decreased in hippocampus in patient with multiple sclerosis. PMID: 23595422
- The rs557762 and the TT haplotype in the 11th haplotype block of the GRIA3 gene were associated with feelings of guilt in females. PMID: 22429480
- the promoter methylation of the GMR2 and GMR5 genes greatly decreased the risk of schizophrenia, and the expression level of the GRM2, GRM5, and GRIA3 genes increased significantly in patients in comparison to healthy controls. PMID: 23149219
- SNP rs687577 associated with sleep duration and depression risk in Finnish women PMID: 21966062
- GRIA3 plays a role as a mediator of tumor progression in pancreatic cancer downstream CUX1. PMID: 20689760
- Two variants in the regulative regions of GRIA1 (rs2195450) and GRIA3 (rs3761555) genes resulted strongly associated with MA (P = 0.00002 and P = 0.0001, respectively), but not associated with MO PMID: 20579352
- AQP3 gene isn't the responsible gene for this pedigree with auditory neuropathy. PMID: 20564826
- This study demonistrated that the level of metabotropic glutamate receptor 2/3 is elevated in the prefrontal cortex in patient of major depression disorder. PMID: 19945495
- The mGlu3 receptor is located on a number of GABAergic interneurons throughout the brain. mGlu3 receptor is one of two primary mGlu receptors that modulate the function of glia. The mGlu3 receptor is present as a postsynaptic receptor as well. PMID: 19933774
- T lymphocytes from normal individuals, an alloprimed human T cell clone, and human T leukemia (Jurkat) cells all express high levels of GluR3, identical in sequence with brain GluR3. PMID: 12682273
- cleavage and release to the extracellular milieu of the GluR3B peptide may in principle increase its antigenicity PMID: 17202328
- study provides the genetic and functional evidence that mutant iGluR3 with altered kinetic properties is associated with moderate cognitive impairment in humans PMID: 17989220
- results support the involvement of genes GRIA3 and GRIK2 in antidepressant treatment-emergent suicidal ideation PMID: 18593792
- Aberrant GRIA3 transcripts with multi-exon duplications in a family with X-linked mental retardation are reported. PMID: 19449417
顯示更多
收起更多
-
相關疾病:Mental retardation, X-linked 94 (MRX94)
-
亞細胞定位:Cell membrane; Multi-pass membrane protein. Cell junction, synapse, postsynaptic cell membrane; Multi-pass membrane protein.
-
蛋白家族:Glutamate-gated ion channel (TC 1.A.10.1) family, GRIA3 subfamily
-
數據庫鏈接:
Most popular with customers
-
-
YWHAB Recombinant Monoclonal Antibody
Applications: ELISA, WB, IHC, IF, FC
Species Reactivity: Human, Mouse, Rat
-
Phospho-YAP1 (S127) Recombinant Monoclonal Antibody
Applications: ELISA, WB, IHC
Species Reactivity: Human
-
-
-
-
-